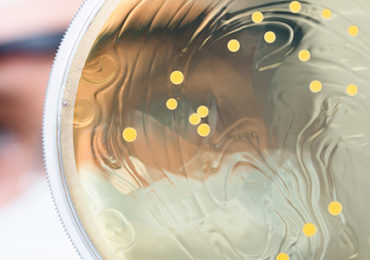

Voeding draagt bij tot een verhoogd risico op bepaalde soorten kanker, zeker in de context van obesitas.…
Pathologieën
Overgewicht schaadt de lever op zeer jonge leeftijd
Gewichtstoename in het begin van de kindertijd zou halfweg de kindertijd al een negatieve impact hebben op de gezondheid……
Kunnen bessenpigmenten helpen tegen kanker?
Uit een nieuwe Finse studie blijkt dat natuurlijke bessenpigmenten, ook bekend als anthocyanen, de functie van het enzym……
Impact van walnoten op darmmicrobiota
Noten zijn goed voor je! Eerdere studies hebben de positieve gezondheidseffecten van noten aangetoond, waaronder hoofdzakelijk het verminderen……
Kan kaas helpen tegen colitis?
Het klinkt ongelooflijk. Vaak krijgen personen met spijsverteringsstoornissen immers de raad om geen zuivelproducten te eten. Nu blijkt echter dat……
Eén keer vet eten is al slecht voor het hart
Een maaltijd met een te hoog vetgehalte verstoort tijdelijk de fysiologie…
Is pasta dan toch geen dikmaker?
Goed nieuws voor pastaliefhebbers. Al jarenlang wordt er beweerd dat pasta een dikmaker is. Echter bewijst een Canadese studie het tegendeel……
Vezels in de strijd tegen intestinale hyperpermeabiliteit
Volgens een Zweedse studie zou suppletie met bètaglucanen een positieve impact hebben op de……
Obesitas jaagt kosten gezondheidszorg VS de hoogte in
In de Verenigde Staten kampt ruim 30% van de bevolking met obesitas. De schadelijke gevolgen voor de gezondheid……
Microbiota en obesitas: signatuur in het plasma
Volgens een Zweedse studie is de waargenomen aantasting van de microbiota bij obesitas geassocieerd met de aanwezigheid van bepaalde metabolieten……